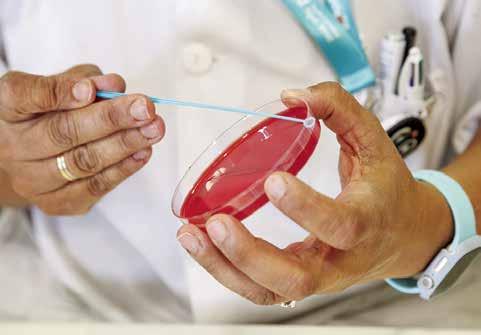

Síndrome de Turner







Ciudad Juárez/Matamoros (México), (EFE).- La nueva política de Estados Unidos para expulsar de inmediato a venezolanos que lleguen por tierra, con el consentimiento del Gobierno mexica no, inquieta a migrantes y activistas en la frontera norte de México, donde los alber gues ya están saturados.
Venezolanos y directores de albergues en
Ciudad Juárez y Matamoros expresaron a EFE su incertidumbre por lo que ocurrirá después de que el Departamento de Segu ridad Nacional estadounidense (DHS, en inglés) anunció el miércoles la deportación de los venezolanos que lleguen a la fron tera bajo el Título 42. “Lo primero que se tiene que meditar es si conocen la realidad de la frontera, los albergues no están solos, esos acuerdos es tán entre Estados Unidos y México cuando hay una crisis migratoria”, declaró a EFE el padre Javier Calvillo, director de la Casa

del Migrante de Juárez, ciudad fronteriza con El Paso, Texas.


El sacerdote expresó que está la duda de quién apoyará con los gastos a los indocu mentados que devuelvan a Juárez, donde espera que los tres niveles de Gobierno ayuden con esta problemática.

“Parece que no les interesan los migrantes. La pregunta es qué pasará con todos los venezolanos. Fue un acuerdo entre los Go biernos, ojalá y haya una acción de ellos”, remarcó.
“
Un diagnóstico temprano puede resultar en algo bueno, pues las mujeres pueden presentar síntomas leves hasta la adolescencia o los primeros años de la edad adulta”

Tradition since 1986
Division of online media group, inc.
 José Luis B Garza publiSher Paula Freed regiSter agent
Lourdes Castañeda graphic and edition deSigner Noemí Lamela editorial aSSiStant
Andrés Oppenheimer
José Luis B Garza publiSher Paula Freed regiSter agent
Lourdes Castañeda graphic and edition deSigner Noemí Lamela editorial aSSiStant
Andrés Oppenheimer
Si las Naciones Unidas quiere evitar hacer nuevamente el ridí culo, debería evitar que Venezuela sea reelegida para una banca en el Consejo
PRINTING: The Monitor Commercial Print
Founded in 1986, published weekly by El Periodico USA, Inc., committed to provid ing with quality news and information in Hidalgo, Starr, and Cameron counties, serv ing to the Rio Grande Community.
Periodical postage paid McAllen, Texas, 78501
TO: El Periodico USA, 801 E. Fir Av., McAl len, Texas, 78501. The opinions expressed in the editorials of this publication rep resents the position and ideology of this newspaper; the opinions expressed by our writers and guest columnists are not nec essarily the opinions of the management, staff or ownership of El Periódico U.S.A., the contents of which they are solely and exclusively responsible. Letters from our readers are welcome and will be published, subject to space availability as long as they are signed and have a proper return ad dress. All letters will be reviewed and edit ed for offensive language, slander, and def amation and for proper grammar, spelling and accuracy, according to our style.
El Periódico U.S.A., no es responsable por traducciones hechas por agencias de publicidad.
Representante legal en México: José Luis B Garza
Ph. (956) 631-5628 Fax. (956) 631-0832.
de Derechos Humanos de la ONU. Por loco que parezca, Venezuela, uno de los peores violadores de derechos humanos del mun do, ya es miembro del Consejo, y puede ser reelecta por otros tres años.
El régimen del dictador venezolano Nicolás Maduro se está postulando para una de las 14 bancas en el Consejo, que tiene 47 miembros. Venezuela, Chile y Costa Rica están compitiendo por los dos asientos res ervados en el Consejo para América Latina y el Caribe.
La Asamblea General de la ONU, de 193 miembros, elegirá a los nuevos miembros del Consejo en una votación secreta el mar tes 11 de octubre en Nueva York.
En un mundo lógico, Venezuela debería tener cero posibilidades de ocupar una ban ca en el Consejo.
Según un reporte del mes pasado de la Mis
ión Internacional Independiente de la ONU sobre la situación de los derechos humanos en Venezuela, sus investigadores encon traron evidencia de “un plan orquestado por el presidente Nicolás Maduro y otras personas de alto nivel para reprimir la oposición al gobierno, incluso a través de la comisión de gravísimos actos de tortura que constituyen crímenes de lesa humanidad”. El nuevo informe citó “asesinatos consis tentes con patrones previamente documen tados de ejecuciones extrajudiciales”. En 2019, la oficina del Alto Comisionado de las Naciones Unidas para los Derechos Humanos había informado que los es cuadrones de la muerte de Maduro eran responsables de más de 7,000 asesinatos extrajudiciales en los 18 meses previos, durante protestas masivas en Venezuela. Alrededor de 6.8 millones de venezolanos, o el 20% de la población, ha huido del país desde 2014.
Pero debido al absurdo mecanismo de votación para el Consejo de Derechos Hu manos de la ONU, bajo el cual cualquier país puede postularse para una banca sin importar su historial de derechos humanos, no se puede descartar que Venezuela pueda ser reelegida este año.
“Entre el 60% y las dos terceras partes de los 193 países miembros de la Asamblea General son problemáticos o terribles en materia de derechos humanos, y muchos de ellos se protegen entre ellos”, me dijo Louis Charbonneau, de la organización de dere chos humanos Human Rights Watch.
Además, China, Rusia, Cuba y otras dict aduras tienen muchos aliados en la ONU, y constituyen una fuerza de cabildeo muy fuerte en la ONU, agregó Charbonneau. Sin embargo, también hay razones para esperar que la candidatura de Venezuela pueda ser derrotada. A diferencia de lo que ocurrió en la votación del 2019, cuando Costa Rica presentó su candidatura al Con sejo a último minuto, esta vez Costa Rica se ha postulado con mayor anticipación, y ha montado una mejor campaña para ganar una de las dos bancas latinoamericanas.
Cualquiera que sea el resultado de la votación del 11 de octubre, es urgente reformar el Consejo para evitar que puedan candidatearse las dictaduras. En este mo mento, el 60% de los miembros del Consejo —incluyendo Venezuela, Cuba y China— no cumplen con los estándares mínimos de derechos humanos, según el grupo de derechos humanos UN Watch, con sede en Ginebra.
Como mínimo, la Asamblea General de la ONU debería prohibir que los países que están bajo investigación o que han sido san cionados por el Consejo de Derechos Hu manos se postulen como candidatos para bancas en ese organismo.
Bajo el sistema actual, las dictaduras mue ven cielo y tierra para ser integrantes del Consejo, y poder protegerse de las investi gaciones de derechos humanos en su con tra.
No es inusual que las dictaduras le digan a los países democráticos en los pasillos de la ONU: “Si tu votas por mí para una ban ca en el Consejo de Derechos Humanos, yo voto por tí para una banca en el Consejo Económico y Social”. Este perverso sistema de protección mutua entre las dictaduras dejaría de funcionar si se prohíbe que los países que están siendo investigados o han sido sancionados por el Consejo formen parte del mismo.
A menos que la ONU adopte estas reformas, los violadores de derechos humanos como Venezuela, Cuba y China seguirán siendo elegidos, y el Consejo de Derechos Hu manos de la ONU seguirá siendo un chiste.
Pa’ mañana puede ser demasiado tarde. En los Estados Unidos, 9 de cada 10 personas que han muerto por COVID tenían 50 años o más. Recibe hoy una vacuna actualizada contra el COVID. Porque pa’ mañana puede ser muy tarde. Especialmente si padeces diabetes o presión alta.
Encuentra vacunas actualizadas contra el COVID en vacunas.gov

dores, distribuidores y consumidores de Estados Unidos y México, al evento temático anual “A Taste of Trade” con el cual se celebró el inicio de la temporada de frutas y verdu ras 2022-2023.
La reunión contó con una variedad de frutas y ver duras frescas exhibidas de manera brillante y chefs locales que prepararon muestras de comida de las exhibiciones de productos.

El Puente Internacional de Pharr continúa siendo el puente número 1 para cru ces de productos agrícolas en la nación, con más del 65 % de todos los productos agrícolas de México cruzan do a través de Pharr.
“Alimentamos al mundo a través de nuestro puente”, dijo el alcalde de Pharr, Dr. Ambrosio Hernández, “Todo va desde este puente a través de los Estados Uni dos, desde la costa este, el medio oeste y finalmente termina en otros países como Alemania y estamos
muy orgullosos de eso”, continuó. “Hoy también reconoc emos y celebramos el arduo trabajo de nuestro personal de puente por el gran éxito que continúa experimentan do nuestro puerto de entrada”, agregó Hernández. “Se necesita un equipo y hemos estado trabajando diligen temente con muchos socios para garantizar que nuestro puente continúe teniendo la infraestructura, los recursos y los fondos para satisfacer nuestras necesidades futuras”, dijo.
En promedio, el Puente Internacional de Pharr cruza 200,000 envíos de productos por año. Frutas y verduras frescas, como aguacates, piñas, mangos, tomates, zanaho rias y más, pasan por el puente todos los días.

“Cada año, nuestro evento anual continúa creciendo y es tamos muy orgullosos de tener la oportunidad de mostrar nuestro poder comercial, resaltar nuestras asociaciones binacionales y celebrar nuestra clasificación de produc tos entre nuestros muchos socios logísticos y de produc tos”, dijo Bazán. Como parte de nuestro tema “A Taste of Trade”, presentamos varios platos preparados por chefs y restaurantes locales utilizando productos frescos de nues tro puente”, agregó. “Esto es algo nuevo que agregamos este año y esperamos que todos hayan disfrutado viendo visualmente cuántos de nuestros productos agrícolas pas an por Pharr”, continuó.
Estados Unidos se ha mantenido consistentemente como el socio comercial número uno de México en productos y bienes. La ubicación geográfica ideal de Pharr ha resul tado en una asociación exitosa y fructífera entre los dos países y en el crecimiento de su capacidad de comercial ización de productos agrícolas que rompe nuevos récords año tras año.
“El comercio con México sustenta casi 500,000 empleos”, dijo el senador Juan “Chuy” Hinojosa durante su inter vención. “Texas no podría ser tan fuerte económicamente sin que México sea un socio”, agregó el Senador Hinojosa. La celebración concluyó con el corte ceremonial de la fru ta y la distribución de productos frescos a los invitados.
glés) se encuentran entre las 406 escuelas de todo el país que serán nombradas como las escuelas más saludables de Estados Unidos para el año escolar 2021-2022.
El reconocimiento es otorgado por Alliance for a Healthier Generation, una organización líder en salud infantil, que celebra la dedicación de las escuelas para apoyar la salud y el bienestar de los estudiantes, el personal y las familias.

Las escuelas son reconocidas por implementar prácticas como fortalecimiento de la salud y el aprendizaje socio emocional, cultivar el bienestar del personal, aumentar la participación de la familia y la comunidad, mejorar la nu trición y el acceso a los alimentos, implementación de la
de bienestar escolar local, fomento de la edu cación y la actividad física, enriqueciendo la educación para la salud, promoción de escuelas libres de tabaco y apoyo a los servicios de sa lud escolar.
Mission CISD es el cuarto distrito con más recono cimientos. La Escuela Pri maria Alton y la Academia de Medios y Comunica ciones de la Escuela Pri maria Waitz son reconocid as como All-Stars en la lista de las escuelas más salud ables de Estados Unidos por implementar las mejores


prácticas en las nueve categorías de salud.


“Teníamos un historial muy sólido de apoyo a las iniciativas de salud de los estudiantes a través de Alliance for a Health ier Generation antes de que comenzara la pandemia”, ex plicó la superintendente del distrito, Dra. Carol G. Pérez.
“Saber que nuestros campus han podido mantener un en foque en el bienestar cuando regresamos a un año escolar desafiante el año pasado, dice mucho sobre el personal de nuestro campus. Su compromiso continuo para tratar de satisfacer todas las necesidades de los estudiantes es digno de elogio”.
En momentos en que las comunidades inmigrante e hispana, al igual que otras minorías, están en la mira del racismo de un Partido Republicano extremista, resulta triste y deleznable cuando el prejuicio proviene de políti cos latinos y demócratas que irónicamente han denuncia do al otro bando por sus posturas discriminatorias.
El escándalo de marca mayor más reciente se desató cuan do fue revelada una conversación grabada hace un año entre la ahora ex presidente del Concejo Municipal de LosÁngeles, Nury Martínez, y los concejales Kevin de León y Gil Cedillo, así como el jefe de la Federación Laboral delCondado de Los Ángeles, Ron Herrera. Fue en el marco de una reunión sobre redistribución de distritos donde se for mularon comentarios racistas sobre el hijo afroamericano de un concejal anglosajón, Mike Bonin. Pero también hubo comentarios sobre las comunidades indígenas, particular mente los oaxaqueños, a los que Martínez tildó de “feos”. También hubo comentarios homofóbicos.
Las expresiones son tan hirientes, que la sola idea de que ese grupo de políticos se haya ostentado durante tanto ti empo como el “liderazgo” de la comunidad de una de las ciudades más latinas de todo Estados Unidos como es Los Ángeles repugna de inmediato. La comunidad oaxaqueña, por otro lado, es una de las de mayor presencia cultural en el estado de California y sus festivales más importantes, como la Guelaguetza –que en zapoteco expresa la idea de participar, cooperar, ofrendar, ayudar, ser solidario—son celebrados desde hace décadas cada año en diversas ci udades del estado, donde se muestra la grandeza de ese pueblo que ha luchado por preservar sus raíces, aun fuera de sus lugares de origen. ¿Martínez, De León, Cedillo y Herrera eran conscientes de esto al momento de expresar su verdadera opinión sobre un pueblo que también les ha dado votos?
De hecho, que esa conversación se grabara hace un año y que se filtrara ahora por quién sabe qué motivaciones políticas no le resta ningún peso, pues son comentarios que no tienen cabida en conversaciones públicas ni privadas.
¿Con qué moral y con qué cara pueden estos llamados “lí deres latinos” denunciar el prejuicio hacia las comunidades que dicen representar, si ellos piensan igual que quienes los atacan?
Ahora ellos mismos saben cuál es la mejor manera de acabar con una carrera política en un minuto, como en ese juego de “Serpientes y Escaleras” —y como mexicoamericanos lo de ben conocer muy bien—, que cuando se piensa que se está hasta arriba o a punto de llegar a la meta, se atraviesa una terrible serpiente que hace descender al participante hasta el nivel más bajo del juego.
Incluso el propio presidente Biden, a través de su portavoz Karine Jean-Pierre, opinó que todos ellos deben renunciar, calificando su lenguaje como “inaceptable” y “espantoso”.
A través del país, grupos cívicos, de derechos civiles y pro inmigrantes están enfrascados en una lucha sin cuartel con tra el racismo que emana de candidatos y líderes republica nos, quienes afirman que en la frontera con México hay una “invasión”, que aseguran que los demócratas quieren “re emplazarlos” con minorías para arrebatarles su poder políti co. Y otros más usan a desesperados migrantes en busca de asilo como peones de un maquiavélico juego de ajedrez político, como están haciendo los gobernadores de Florida y Texas, Ron DeSantis y Greg Abbott, respectivamente.

No obstante, de figuras racistas y antiinmigrantes se puede
esperar lo que sea. Pero que representantes de esas co munidades atacadas exhiban conductas similares —sola mente que lo hacen por lo bajo sin sospechar que los están grabando— es hipócrita y es más despreciable.
Porque no es normal discriminar; no está bien rechazar a alguien con actitudes racistas; no es correcto señalar la “paja en el ojo ajeno”, ni en privado, ni en público. Pero sobre todo, no cuando te dices “líder” de una o más mi norías; no cuando eres pro inmigrante y buscas la igual dad entre las comunidades; no cuando tus ancestros sufri eron abusos incontables, y callarlos, para que tú llegaras hasta donde estás.
Martínez renunció a la presidencia del Concejo Municipal y dijo que se acogerá a una licencia. Mientras que los dos concejales ofrecieron disculpas, aunque los llamados para que los tres renuncien a sus puestos son cada vez mayores.
Los tres son mexicoamericanos y los tres han contado sus respectivas historias familiares en diversas oportunidades, con similitudes de un pasado de sufrimientos. ¿Qué ten drán que decir ahora cada vez que regresen a casa?
Pero tristemente este caso no es aislado. Quienes somos latinos conocemos de primera mano el prejuicio rampante que se da a diversos niveles entre los propios latinos: unas nacionalidades desprecian a otras, y entre las mismas na cionalidades existe prejuicio de clase, de raza, de color, de situación migratoria. Es algo generalizado que inclu so muchas veces se intenta “suavizar” tratando de que las burlas y los comentarios sean “jocosos”. No es poco frecuente, por otra parte, escuchar en las conversaciones entre latinos cuando reivindican su pasado blanco y eu ropeo, por encima de la realidad geográfica latinoameri cana en la que nacieron y crecieron.
Esto ha sido y es así en nuestros respectivos países. Lo curioso es que cuando llegan a Estados Unidos y sienten el prejuicio y la discriminación de parte de otros sectores, entonces acusan a los demás de racistas; y los políticos que nos representan también alzan su voz, y aunque en su mayor parte son sinceros y genuinos, también abundan figuras como Martínez que pretenden predicar la moral en calzoncillos.
Esto, por supuesto, marca desde ya un llamado de atención a quienes pretendan autonombrarse “líderes” de una comunidad como la latina, que lo que menos necesi ta en estos momentos cruciales para su futuro en Estados Unidos es contar con representantes que en privado son todo lo contrario de lo que predican en público. Y eso es más que vergonzoso.
Es tiempo de hacer un examen de conciencia a todos los niveles, porque el racismo y el prejuicio deben condenarse vengan de quien vengan.
Austin, Tx.- El gobernador de Texas, Greg Abbott, anunció que la ciudad de Edinburg, después de haber completado el proceso de certificación de varios pasos, ha sido desig nada como una Comunidad Amigable con la Música por la Oficina de Música de Texas (TMO, por sus siglas en inglés). El programa Comunidad Amigable con la Música busca fo mentar el desarrollo económico relacionado con el negocio

de la música en las ciudades y comunidades de Texas. “La música es una gran parte de la marca Texas y está profundamente arraigada en las tradiciones culturales de nuestro gran estado”, dijo el Gobernador Abbott. “Con el apoyo de la Oficina de Música de Texas, la industria de la música en Texas creó más de 210 000 empleos permanen tes directos e indirectos en comunidades de todo el Estado de la Estrella Solitaria y generó $27 300 millones en activ idad económica en 2019. Comunidades amigables con la música certificadas por la Oficina de Música de Texas se toman en serio la atracción y el desarrollo de la industria musical local para estimular la creación de empleo y el cre cimiento económico. Felicito a la Ciudad de Edinburg por obtener la designación de Comunidad Amiga de la Música, y espero trabajar juntos en su éxito continuo”.
“La música no sólo nos une, también trae alegría, refle ja diferentes culturas y es buena para el alma”, dijo el Senador Juan “Chuy” Hinojosa. “La música también es una gran herramienta de desarrollo económico que mejora nuestras comunidades y mejora nuestra calidad de vida. Aprecio el liderazgo del gobernador Abbott en la promo ción de la música en Texas. Felicito a la ciudad de Edinburg por obtener la designación de comunidad amigable con la
música que beneficiará tanto a las empresas como a los residentes de nuestra comunidad”.
“Edinburg es conocida en el Valle del Río Grande como una joya cultural: desde el Museo de Historia del Sur de Texas hasta el Festival Internacional de Cine del Sur de Texas y el Museo de Motocicletas del Sur de Texas, siem pre hay algo culturalmente fascinante en marcha”, dijo el representante Bobby Guerra. “Ahora que Edinburg se ha ganado la prestigiosa designación de Music Friendly Com munity, la comunidad puede tallar otra faceta en la joya que es Edinburg. Como músico, conozco personalmente a los increíbles artistas de nuestra comunidad y estoy emo cionado de compartir su talento con el resto de Texas”. Edinburg se une a más de otras 30 ciudades de Texas que han recibido la designación oficial de “Music Friendly Community”, incluidas Abilene, Alpine, Arlington, Austin, Bastrop, Brenham, Bryan, Conroe, Dallas, Denison, Den ton, Dripping Springs, El Paso, Fort Worth, Grand Prairie, Harker Heights, Lindale, Lubbock, McAllen, McKinney, Na cogdoches, New Braunfels, Odessa, Port Aransas, Round Rock, Salado, San Angelo, San Antonio, San Marcos, Ste phenville, Victoria, Vidor, Waco, Waxahachie y Wimberley.
En cumplimiento con el Plan Consolidado para la Planificación y Desarrollo Comunitario (CDBG), las ciudades mencionadas debajo llevarán a cabo una audiencias públi cas para solicitar la opinión de las partes interesadas en las necesidades de la ciudades bajo el Programa Urbano del Condado de Hidalgo, del año fiscal 36 (2023)
Los objetivos generales del Plan Consolidado son el fortalecimiento de las asociaciones con jurisdicciones a fin de ampliar y fortalecer las alianzas entre todos los niveles del gobierno y el sector privado, incluyendo las organizaciones sin fines de lucro y, a fin de que puedan proporcionar una vivienda digna, para establecer y mantener una vida adecuada en el medio ambiente, y para ampliar las oportunidades económicas para todos los ciudadanos, en particular para las personas con ingresos muy bajos.
La audiencia pública para la Ciudad de Progreso se llevará a cabo el martes 25 de octubre 2022 a las 6:00 P.M.. en la siguiente ubicación: Municipalidad de la Ciudad de Progreso ubicado en el 300 N. Business FM 1015, Progreso, Texas 78579. Para obtener más información, por favor venga a nuestra oficina de la ciudad o llame al (956) 565-0241. Los comentarios escritos pueden hacer enviados a: Alcalde Gerardo Alanis de la Ciudad de Progreso al P.O. Box 699, Progreso, Texas 78579. Asignación esperada de $257,515.00.
A continuación se muestra una lista parcial de las actividades elegibles. Necesidades de establecimientos públicos Centros para personas de la tercera edad Centros para jóvenes Instalaciones del vecindario Instalaciones de parques y recreación Instalaciones de salud Instalaciones para el cuidado de niños Instalaciones de estacionamiento
Necesidades de mejoras de infraestructura Mejoras de drenaje de inundaciones Mejoras de agua Mejoras de alcantarillado Mejoras de calles
Necesidades de Servicios Públicos Servicios para personas de tercera edad Servicios para discapacitados Servicios para jóvenes Servicios de cuidado infantil
Necesidades de vivienda de emergencia Necesidades de vivienda Planificación de la Comunidad

Administración del Programa
Necesidades de desarrollo económico Asistencia Técnica
Aplicación del código
Pintura con base de plomo / Reducción de Riesgo
Es el objetivo del Condado de Hidalgo para cumplir con la Sección 504 de la Ley de Rehabilitación de 1973, según enmendada, los Americanos con Discapacidades de la Ley de barreras arquitectónicas (ADA) de 1990 y la Ley ADA Enmienda de 2008, la Ley de Equidad de Vivienda, y Con todo respeto. Las personas con discapacidades / minusválidos, que no hablan inglés o con un dominio limitado del inglés (LEP) que pueden requerir un intérprete se les proporcionarán previa solicitud llamando al (956) 787-8127 por lo menos con tres (3) días de anticipación. Las personas sordas, con problemas de audición, sordo-ciegos o del habla discapacitados pueden utilizar Relay Texas al (800) 735-2989 para llamar al Programa del Condado de Hidalgo Condado Urbano (UCP) y los arreglos de solicitud con el fin de participar en el ciudadano pro ceso de participación. El Programa Urbano del Condado de Hidalgo no discrimina en base al estado de discapacidad en la admisión, el acceso o el tratamiento en sus programas o actividades con asistencia federal.
Programa Urbano del Condado de Hidalgo 1916 Tesoro Street, Pharr, Texas 78577
No es un secreto que los latinoamericanos somos parte importante de la economía de EEUU, pero ahora está de finitivamente demostrado. Actualmente, somos el principal motor de progreso poblacional. También una pieza clave en el crecimiento económico. En 2020 representábamos el 18,7% de la población total de EEUU. En esta ocasión, los que vivimos en EEUU nos hemos con vertido en tema de tendencia, y no es para menos. Reci entemente se anunció que el trabajo de los latinos tiene el tercer lugar en crecimiento acelerado, de entre los diez más relevantes a nivel mundial, comparado con las principales economías.
De acuerdo con diversos investigadores, el PIB producido por los latinos en EEUU alcanzó 2,8 billones de dólares du rante 2020. Este crecimiento es tan impresionante que, si nuestra comunidad perteneciera a un país independiente, sería el quinto más importante, después de EEUU, China, Japón y Alemania.
Pero lo que más ha impresionado al mundo no es el volu men, sino la rapidez con la que se ha logrado el crecimien to. La población latina alcanzó una rapidez de 2,6 veces más que la no latina ¿A qué se debe esto?
Según diversos estudios, algunas características que permi tieron a los latinoamericanos alcanzar volumen y rapidez en el crecimiento económico fueron:
1-La actitud resiliente adquirida tras el impacto de la pan demia. 2-La alta ética del trabajo duro. 3-El optimismo 4-La autosuficiencia
Hemos demostrado, con nuestro trabajo, lo que podemos aportar al país de las oportunidades: somos dedicados, con stantes, persistentes y entregados; pero aún nos falta algo muy importante, tenemos que empoderarnos, para proyec tar más confianza; amarnos, para nunca bajar la cabeza cuando se nos discrimine; valorarnos y respetarnos, porque sólo a través del amor propio podemos proyectar esa confi anza que genera respeto. Como latinoamericanos, aún nos faltan muchas cosas que lograr, pero definitivamente éste es un gran paso que nos acerca a que se respeten nuestros derechos y se nos dé un trato verdaderamente digno.
Más en: www.elperiodicousa.com

Conforme se acerca la fecha del ocho de noviembre del presente año en que se llevarán a cabo importantes elec ciones en los Estados Unidos donde se trata de conquistar la mayoría del Congreso, actualmente en manos demócra tas, en particular en el Valle de Texas se ha intensificado la lucha entre los candidatos de los partidos Republicano y Demócrata.
Durante las últimas semanas los contendientes se han en frascado en exhibir a sus oponentes con ataques en los que se cuestionan diversos aspectos sobre su conducta, posición ante algunos temas en específico, fundados o no, que son esgrimidos como arma propagandística, pero no se había cuidado el tratar de proyectar la imagen positiva de quienes abanderan las causas partidistas. Independientemente de la preferencia que se pudiera ten er, los abanderados demócratas parece que se encuentran activándose en el propósito de acudir ante los medios in formativos, con la invitación respectiva, para exponer sus ideas. Así, la aspirante a congresista por el Distrito 15,
Michelle Vallejo, junto con la candidata a fiscal general de Texas (Attorney General), Rochele Garza, convocaron a una conferencia de prensa en McAllen hace unos días. Lo hicieron con el propósito de abordar como tema central y prioritario el acceso al aborto y lo que consideran sus dere chos reproductivos.
Independientemente de la opinión que se tenga sobre el ya controversial tema, se eludió lo relacionado con migración, presupuesto, pobreza, economía y salud en general, por ci tar ejemplos.
Muchos quisieran ver un debate entre aspirantes a congre sistas en la franja fronteriza texana, donde predominan las nominaciones femeninas, y que se hicieran exposiciones, si se quiere encontradas o muy encontradas, pero que fi nalmente permitan normar el criterio de los electores y, de alguna forma, estimular la participación de éstos en el proceso que se avecina para romper la constante de la baja participación en las elecciones, donde, pese a que hay un proceso que permite la votación anticipada, por correo y el día final, es muy poca la respuesta de los ciudadanos que, por otra parte, puedan ejercer su derecho a votar, que no sólo permite decidir y ser debidamente representado sino que hace valer un enorme privilegio, desafortunadamente no siempre utilizado.
Cuando parecía que las aguas políticas habían tomado su nivel en Tamaulipas, la inesperada muerte del senador por la entidad tamaulipeca Faustino López en un accidente au tomovilístico, agitó de inmediato las fuerzas y figuras políti cas que se consideran que pueden aspirar a sucederlo en el puesto.
El llegó a la Cámara Alta sustituyendo al actual gobernador de Tamaulipas, Dr. Américo Villarreal Anaya, quien dejó
dicha titularidad legislativa para ser candidato a goberna dor quien, tras ganar la elección, ya dispone como man datario estatal.
Salvo que el Senado, tras hacer la declaratoria de ausencia definitiva del titular de la posición senatorial, no tome una decisión no prevista o inesperada, tendrá que convo carse a una elección que tendría lugar los primeros meses del 2023.
Por lo pronto la atención se concentra en la visita que hará el presidente de la República, Andrés Manuel López Ob rador, a Cd. Victoria, tras haber hecho una visita apenas la semana anterior a Cd. Madero.
Lo significativo es que acudirá con todo el gabinete presi dencial y se espera que se proporcionen recursos extraor dinarios al estado para una serie de acciones y comprom isos del gobierno de Villarreal Anaya.
Hay quienes ven en la visita presidencial una posibilidad de que haya un indicador que oriente sobre quién podría ser el candidato de su partido, Morena, a la elección ex traordinaria para senador.
Lo que sí es patente, es el fuerte apoyo que está recibiendo el Dr.Villarreal Anaya de parte de la Presidencia. Se lleva a cabo con la visita presidencial la celebración de la ya con stante conferencia matutina presidencial, conocida popu larmente como “La mañanera”. Sería la primera ocasión que se celebra en tierras tamaulipecas con un goberna dor de Morena y hay gran expectación de los compañeros periodistas por asistir. Algunos ya están pensando en las preguntas adecuadas. Ojalá y no se vean obstaculizados por “periodistas” que suelen participar para hacer cues tionamientos “a modo” o, para utilizar el argot beisbolero, le tiran la bola de “globito” para que no batalle en batear o macanear. En Tamaulipas y Cd.Victoria no es la excepción, hay calificados representantes de medios informativos acreditados que seguramente tendrán cuestionamientos importantes dignos de ser tomados en cuenta.
El racismo es una de las más indignantes formas de discriminación porque pre supone la superioridad de una raza o etnia sobre otra y asigna un absurdo esquema de valores personales basados en el color de la piel.
Por supuesto, todos sabemos que los his panos venimos en todos los colores y po demos ser de cualquier raza, por eso ser latino alude en realidad a nuestra etnici dad. Pero más allá de cualquier definición académica, casi todos hemos sido víctimas de racismo o discriminación. Las estadísti cas anuales del FBI sobre crímenes de odio son una evidencia inobjetable.
Pero cuando ese racismo se practica entre los propios latinos, o más aún, entre fun cionarios latinos electos, es una conducta aberrante y reprochable.
Un estudio del Centro Pew encontró que cuatro de cada diez adultos latinos confe saron haber experimentado personalmente discriminación o trato injusto por parte de otros latinos, y que tener el color de la piel más oscuro o haber nacido fuera de los
Estados Unidos, están asociados con una probabilidad creciente de experimentar este tipo de discriminación. Sólo el 25% de latinos con color de piel más claro dice lo mismo.
Y los latinos nacidos en Puerto Rico, centro américa y sur américa, son más propensos a decir que sufrieron discriminación o trato injusto por parte de alguien de descenden cia latina pero nacido en alguno de los 50 estados de EE. UU. o el Distrito de Colum bia, de acuerdo con Pew.
Esto viene al caso por el escándalo de que cuatro latinos, incluida la presidente del Concejo de Los Ángeles Nury Martínez, los concejeros Gil Cedillo y Kevin de León y el líder sindical Ron Herrera, fueron grabados en 2021 durante una conversación donde llovió el uso de palabras hirientes y racistas contra negros e indígenas oaxaqueños.
Martínez comparó al hijo negro de un con cejero blanco como “changuito” y a los in dígenas oaxaqueños que residen en Kore antown como “chaparros oscuros”, según reportaron los periódicos Los Angeles Times y The New York Times. Martínez ofreció disculpas y renunció a su liderazgo, pero algunos piden su dimisión total. Herrera
renunció como líder y De León se mostró apenado. Allá su conciencia. Pero como lo demostró el estudio de Pew, el racismo está en todas partes y circula im punemente, no sólo en las calles, sino en nuestros vecindarios y dentro de nuestras familias y hogares, cuando estigmatizamos a nuestros amigos o familiares con palabras despectivas e hirientes por su etnicidad o
color de la piel.
Quienes viven en Los Ángeles están en todo su derecho de exigir la renuncia de cualqui er representante racista.
Pero TODOS estamos en la obligación de asumir y erradicar --empezando por el len guaje-- nuestros propios prejuicios racistas, clasistas y xenófobos. O no tendremos auto ridad moral cuando seamos víctimas de las mismas actitudes discriminatorias que com etemos contra nuestras propias hermanas y hermanos.

Con frecuencia pareciera que este título muestra al autor como automático detractor anti-ruso. No es el caso, se trata del más elemental sentido común.
La invasión de Ucrania, aún en el hipotético escenario que Rusia llegue a aniquilar la oposición heroica de los ucranianos, es un grave error y una ignorancia de la historia por parte de Putin y de sus asesores, si es que los usa. Pero el más grande error por parte del dictador Putin fue subestimar el resentimiento de los seres humanos cuando son sometidos a la fuerza. Esta es otra parte de la historia que Putin está negando. La historia de Ucrania tiene
una larga lista de invasores que se inician desde siete mil años antes de contar el primer año de la vida de Cristo.
Estos invasores incluyen: griegos, eslavos, vikingos, mongoles, polacos, lituanos, tártaros, cosacos, turcos y austriacos. Algunos de estos han repetido sus invasiones.
Fue hasta que Catalina la Grande en el siglo XVIII invadió y consolidó la invasión, que los rusos se han sentido dueños de Ucrania. El recuerdo que tienen los ucranianos de Stalin raya en el peor que cualquier ser humano puede tener de un opresor: transformar por la fuerza al colectivismo, redadas la agricultura en sus ricas tierras, arrestos injustificados, desapariciones, ejecuciones, y abusos de todo tipo.
Muchos de los pro-rusos quieren hacer valer que Rusia tiene derecho a invadir y anexarse Ucrania porque en la historia reciente ha sido el caso que lo han dominado, controlado y explotado. Pero equivale a solamente ver “algo” de la historia e ignorar otra historia, más larga y de muchas maneras más trascendente: La determinación de los ucranianos a ser libres.
Se dice que, para los ingleses en los años gloriosos de su imperio, la India era “la joya de la corona.” Misma analogía se usa para explicar la injustificada guerra provocada por el gobierno de los Estados Unidos vs México en 1846 a 1848. California era la “joya de la corona” de los intereses de Estados Unidos, ya que anexándola podía comerciar con el Oriente a través del Océano Pacífico. Pues Ucrania es la “joya de corona” para Rusia.
La posición estratégica de Ucrania, que tiene la mayor parte de sus tierras planas o de pequeñas colinas, unida a inviernos fríos y veranos lluviosos, hacen que se refiera a ella como el granero de Europa por sus negros y productivos suelos. Con valiosos puertos en dos mares:
El Negro y el Azov, este último el mar menos profundo del mundo se conecta con importantes naciones y a través
del estrecho de Kerch con el mismo Mar Negro. Desde 2014, Rusia se anexó Crimea y con eso excluyó a Ucrania de acceso a ese mar y flagrantemente violó acuerdos binacionales e internacionales sin que nada sucediera. Por más de medio siglo Rusia controló todo su entorno incluyendo Europa del Este. Durante ese período no sólo no impresionó a nadie con su mano de hierro impuesta sobre todo por Brezhnev contra cualquier crítica, disidencia y anhelo de libertad, sino que inspiró odio, desprecio a niveles que son estos países los que más ayudan en la actualidad a Ucrania. Se cree que fue de Bulgaria donde se envió al camión que dinamitó el puente de Crimea, Polonia ha recibido el más grande número de emigrados ucranianos que huyen de la guerra, y sucesivamente todas las naciones que antes tuvieron el yugo soviético tienen la mayor simpatía por Ucrania.
Putin apuesta a que Ucrania se cansará y terminará cediendo en esta guerra, mientras que los Estados Unidos y otras naciones, sobre todo europeas, con los precios altos del gas y otros combustibles terminarán aceptando que “se vuelva” Rusia a anexar a Ucrania. Quizá sea el caso.
Mientras tanto, al ver como una y otra vez Ucrania en su larga historia ha buscado su independencia, como lo han hecho y lo siguen haciendo las sociedades del mundo en todas partes, Putin ignora esta parte de la historia y planea mal su invasión. Ni siglos de dominación han podido apagar la llama de la libertad en los seres humanos.
Además, morirá Putin como villano invasor que hizo malos cálculos. Controlar a Ucrania por la fuerza cuando pudo hacerlo su principal aliado es un grave error de un ignorante de la historia.


El evento insignia de McAllen para brillar más y más
McAllen, Tx.- Por cuarta ocasión, el popular conductor, productor y actor, Mario López, volverá a servir como presentador para la retransmisión del McAllen Holiday Parade, tanto en el mercado general como en los 31 principales mercados latinos de Estados Unidos en todo el país. López también es tará acompañado en la transmisión por Lin da Tovar de H-E-B.
El anuncio fue hecho durante una rueda de prensa convocada por funcionarios de la ciudad de McAllen y organizadores del tradicional desfile navideño.
“Muy divertido, ahora se ha convertido en una tradición, así que acompáñenme en el Polo Sur oficial de Texas para darle a Santa una bienvenida del tamaño de Texas en su cálido hogar lejos del hogar en la hermosa McAllen”, dijo López. “Los veré a ti y a San ta allí este 3 de diciembre. Lo espero con ansias”.
Tovar, Gerente Senior de Asuntos Públi cos de H-E-B, se unió a los funcionarios de McAllen Holiday Parade y destacó la asoci ación de larga data de la cadena de super mercados con el famoso evento navideño, declarando "Aquí, Texas, las vacaciones son mejores". Además del regreso del globo favorito de todos, H-E-Buddy, así como de sus globos decorativos flotantes de 10 pies de altura y su carroza gigante iluminada con productos H-E-B del tamaño de Texas, H-E-B organizará un concurso de extensión de masa de tamal, obsequios nocturnos, degustaciones de sus tamales, buñuelos y
otros productos distintivos de Mi Tienda en Christmas in the Park, el festival gratuito y familiar que se lleva a cabo la noche ante rior al desfile.
Los organizadores también lanzaron una invitación a la comunidad para que sean parte de las festividades de este año de varias maneras, incluida una convocatoria de entradas para el McAllen Holiday Shoe box Parade, voluntarios portadores de pan cartas y manipuladores de globos y bandas de escuelas preparatorias de toda la región para participar en la tradición navideña.
Los voluntarios que manejen globos deben tener 18 años o más, mientras que los por tadores de pancartas deben tener 16 años o más. Todos los voluntarios deben pasar por una verificación de antecedentes y reci birán guantes, camiseta y refrigerios. Todos los voluntarios deben tener una insignia de voluntario un evento programado.
Obtenga más información en www.volun teersotx.org o envíe sus preguntas o in scríbase en pardvolunteers@mcallen.net.
Asimismo, se hizo un llamado a todas las bandas de escuelas preparatorias de la región para participar en el McAllen Holi day Parade. Las bandas participantes reci birán una beca de $1,000 para ayudar con los gastos relacionados con la aparición en el desfile, o simplemente con cualquier otro gasto de la banda. Comuníquese con el Departamento de Parques y Recreación de McAllen para solicitar participar en el desfile.
Los organizadores también les recuerdan a todos en todo el Valle del Río Grande que la convocatoria para participar en el McAllen
Holiday Shoebox Parade aún está abierta y que la fecha límite para participar se acerca rápidamente. Las creaciones deben estar en una caja de zapatos y pueden incluir cual quier tipo de artesanía, juguetes, adornos navideños, luces o innumerables elemen tos para celebrar el "Polo Sur y más allá", el tema de la caja de zapatos y el gran desfile. La caja ganadora se convertirá en un car ro alegórico real para la edición 2023 del McAllen Holiday Parade.
Las creaciones deben presentarse a más tardar el miércoles 23 de noviembre de 2022 a las 3:00 p.m. a la Oficina de Co municaciones de la Ciudad de McAllen, Ayuntamiento de McAllen, 1300 W. Hous ton Ave., 3er piso. Para obtener más infor mación, visite www.mcallenholidayparade. com.
El desfile comenzará a las 6:00 p.m. el sába
do 3 de diciembre de 2022 desde el McAl len Veterans Memorial Stadium, 2001 N. Bicentennial Blvd. Los precios de los boletos comienzan en $10, más las tarifas de servi cio para el estadio o los asientos de la Zona Vuelta para el desfile y se pueden comprar en www.ticketmaster.com o en la taquilla del Centro de Artes Escénicas de McAllen, 801 Convention Center Blvd. También hay muchos asientos gratuitos a lo largo de la ruta del desfile, por orden de llegada. Durante los últimos cuatro años, el Desfile Navideño de McAllen ha sido nombrado el Mejor Desfile del Mundo, y este año ganó el Premio Grand Pinnacle de la Organización Internacional de Festivales y Eventos. El McAllen Holiday Parade también ha sido nombrado el Mejor Desfile de Texas duran te los últimos cinco años por organizaciones internacionales y estatales de la industria de eventos.
South Texas College continúa expandiendo su alcance a través de la frontera con su cuarta asociación de Programas de Crédito Dual que hará que la educación universi taria sea más asequible y accesible para los estudiantes de preparatoria en Reynosa. En una firma reciente con Integrity School de la ciudad de Reynosa, el Memorando de Entendimiento para No Residentes señala que el objetivo es guiar a los estudiantes de penúltimo y último año de Integrity School hacia la educación general, o finalización básica, mientras están en la escuela prepa ratoria, lo que les ayudará a obtener una base de conocimientos en su búsqueda de una educación superior.
El presidente de STC, Ricardo J. Solís, dijo que las asociaciones de crédito dual son al gunas de las más importantes porque plan tan la semilla de una educación superior y las posibilidades de una carrera exitosa en una edad crucial.
“Es un honor tener a Integrity School como socio”, dijo Solís. “South Texas College se compromete a crear oportunidades edu cativas para los estudiantes y fortalecer la preparación universitaria para todos los estudiantes en nuestra región y más allá. Esperamos que esta asociación avance y brinde una educación de la mejor cali dad. Esta colaboración cambiará la vida de muchos estudiantes y sus familias”.

STC e Integrity Schools de Reynosa se han asociado para ofrecer a los es tudiantes de tercer y cuarto año de preparatoria de Reynosa cursos de doble crédito en STC que los preparará para comenzar su viaje educativo superior en STC o en cualquier otra universidad de su elección.
El director de Integrity School, David Martínez Longoria, dijo que está emociona do de trabajar con STC y conectar a sus es tudiantes con la educación superior en los Estados Unidos.
“Muchos de nuestros estudiantes buscan títulos en los Estados Unidos, de hecho, muchos se han matriculado y se han grad uado de STC, pero esta colaboración, esta asociación, abrirá esta oportunidad para
muchos más de nuestros estudiantes”, dijo Martínez Longoria. “Este es un gran prob lema para todos los que estamos involu crados y acercará la posibilidad de ir a la universidad a nuestros estudiantes”.
Agregó: “STC es líder en aprendizaje y tecnología innovadores, por lo que esper amos, junto con la universidad, crear pro gramas de verano que brinden a nuestros estudiantes experiencias prácticas en los campos de ciencia, tecnología, ingeniería y matemáticas (STEM), que les permita avanzar. Gracias STC, sus iniciativas están abriendo fronteras y rompiendo barreras”. Rebecca De León, Decana de Programas de Crédito Dual y Asociaciones de Distritos Escolares de STC, dijo que se espera que la primera generación de esta asociación comience en la primavera de 2023 alla nando el camino de los estudiantes hacia trayectorias profesionales individuales.
“Esto proporcionará una transición fluida para los estudiantes de Integrity School a STC o a cualquier universidad de su elec ción al graduarse de la escuela prepara toria”, dijo De León. “Estas asociaciones están cumpliendo la visión de la universi dad de ser un modelo global en innovación educativa que sirva como catalizador para impulsar la prosperidad regional, el desar rollo económico y la movilidad social de aquellos a quienes servimos”.
Los estudiantes del área de Reynosa pagan una tarifa mínima para inscribirse en doble crédito.
El programa se está expandiendo al sur de la frontera con varias otras escuelas prepa ratorias que ya han expresado interés en asociarse con STC.
Para obtener más información sobre los programas de doble crédito de STC, visite southtexascollege.edu/dual/.

WASHINGTON – El Servicio de Impuestos Internos está enviando cartas a más de 9 millones de personas y famil ias que parecen calificar para una variedad de beneficios tributarios clave, pero que no los reclamaron al presentar una declaración de impuesto federal de 2021.
Muchos en este grupo pueden ser elegibles para reclamar parte o la totalidad del Crédito de recuperación de reem bolso de 2021, el Crédito tributario por hijos, el Crédito tributario por ingreso del trabajo y otros créditos tributar ios, según su situación personal y familiar.
Estas cartas de recordatorio especiales llegarán a los bu zones de correo durante las próximas semanas, se envían a las personas que potencialmente pueden calificar para el Crédito tributario por hijos (CTC), el Crédito de recu peración de reembolso (RRC) o el Crédito tributario por ingreso del trabajo (EITC) pero que aún no han presenta do una declaración de impuestos de 2021 para reclamar
los. La carta, impresa en inglés y en español, proporciona una breve descripción de cada uno de estos tres créditos. “El IRS quiere recordar a las personas potencialmente elegi bles, especialmente a las familias, que pueden calificar para estos valiosos créditos tributarios”, dijo Chuck Rettig, comi sionado del IRS. “Alentamos a las personas que aún no han presentado una declaración de impuestos para 2021 que revisen estas opciones. Incluso si no están obligados a pre sentar una declaración de impuestos, aún pueden calificar para varios créditos importantes”.
Estos créditos y otros beneficios tributarios se ampliaron con la Ley del Plan de Rescate Estadounidense del año pasado y otras leyes recientes. Aun así, la única forma de obtener los valiosos beneficios es presentando una declaración de impuestos de 2021.
Para realizar este envío, la Oficina de Análisis Tributario del Tesoro identificó a las personas que normalmente no tienen un requisito de presentación de declaraciones de impuestos porque parecen tener ingresos muy bajos, según el Formu lario W-2, Formulario1099 y otras declaraciones de terceros disponibles para el IRS.
Las personas pueden presentar una declaración de impues tos incluso si aún no han recibido su carta.
ciones. “Un diagnóstico temprano puede resultar en algo bueno, pues las mujeres pueden presentar síntomas leves hasta la adolescencia o los primeros años de la edad adulta”, informó.
Según la especialista, el Síndrome de Turn er puede generar problemas de desarrol lo, los más comunes son una curvatura hacia adelante de la parte superior de la espalda y propensión a la osteoporosis.
Adicionalmente a éstas, puede causar gran afectación psicológica en las pacientes al impedir cambios sexuales esperados en la pubertad.
Este aspecto puede desencadenar una de tención en el crecimiento y llevar a la in fertilidad en la mayoría de los casos. De acuerdo con la doctora García y los espe cialistas de Novo Nordisk el ST durante la niñez se puede identificar con cuello ancho y de implantación muy lateral. También orejas de implantación baja, pecho ancho con pezones de gran separación, línea de cabello baja en la parte posterior de la cabeza, paladar alto y estrecho y manos y pies angostos.
NotiPress.- El Síndrome de Turner (ST) afecta a uno de cada 2 mil 400 niñas recién nacidas, según cifras del Centro Nacional para la Salud de la Infancia y la Adolescen cia (CENSIA) proporcionadas a NotiPress por Novo Nordisk. Esta enfermedad es una alteración genética originada por la ausen cia parcial o total de un cromosoma X y se presenta sólo en pacientes mujeres. Asimismo, las niñas y mujeres con ST tienen riesgo de nacer con anormalidades
congénitas en corazón y riñones, así como tener infecciones crónicas o recurrentes del oído medio. Igualmente, son propensas a desarrollar problemas cardiovasculares, por ejemplo el ensanchamiento o estre chamiento de la válvula aórtica, hiperten sión arterial, sobrepeso, diabetes, cataratas y otros problemas de salud.

Leticia García, endocrinóloga pediatra y jefe del Departamento de Endocrinología del Hospital Federico Gómez, destacó que
este síndrome no es hereditario, pero puede originar un sin fin de problemas en la sa lud. “Existen una variedad de problemas médicos y de desarrollo en las niñas como una baja estatura, falta de desarrollo sexual o incluso tiroiditis de Hashimoto o huesos frágiles”, apuntó.
A pesar de ser una enfermedad irreversible, la doctora García señaló que se pueden re alizar diagnósticos y tratamientos en edades tempranas para evitar mayores complica
Ya en la etapa de la adolescencia, los si gnos más frecuentes del ST son la baja estatura, insuficiencia ovárica, periodos de crecimiento acelerado propios de la in fancia, impacto en la salud física y mental.
Si las personas identifican la mayoría de los síntomas en sus hijas, los especialistas recomiendan acudir con los médicos es pecialistas para tener un diagnóstico más certero. Esto podría ayudar en gran medi da a las pacientes a evitar mayores compli caciones de salud a mediano y largo plazo durante su desarrollo.

“ Un diagnóstico temprano puede resultar en algo bueno, pues las mujeres pueden presentar síntomas leves hasta la adolescencia o los primeros años de la edad adulta”
AEP 2023 comenzó el 15 de octubre de 2022 y se extiende hasta diciembre 7 de 2022.
¿Cuándo podemos inscribirnos en un plan? Cada año, las personas que son beneficiarios de Medicare, cuentan con el Periodo Anual de Inscripción que se ex tiende desde octubre 15 a diciembre 7. En este tiempo las personas podrán revisar y revaluar su plan actual, cambiar su plan de recetas, cambiar su plan de Medicare Advantage, añadir un nuevo plan o cancelarlo. Los cambios hechos en el Periodo Abierto de Inscripción comenzarán a tener efecto en enero primero del 2023. Si su plan actual está siendo ofrecido el próximo año y no desea hacer cambios, su plan se renovará automáticamente. Recuerde la importancia de revisar su plan cada periodo abierto; asegúrese que sus doctores y hospitales de preferencia estarán cubiertos el próximo año, así como también los medicamentos impor tantes para usted.
Las personas que estén calificando para Medicare por prim era vez, cuentan con el Periodo Inicial de Inscripción (IEP) que abarca 7 meses: Los 3 meses antes de cumplir 65 años de edad, el mes de su cumpleaños 65 y los siguientes 3 meses después de cumplir 65 años.
Hay algunas circunstancias especiales en donde podríamos calificar para enrolarnos en un plan en cualquier parte del año. Por ejemplo, si nos mudamos a otro estado o ciudad en donde nuestro plan actual no sea ofrecido, si calificamos para algún tipo de ayuda extra del Estado o Seguro Social o si perdemos esa ayuda, al terminar la cobertura del plan de un empleador, tener alguna condición crónica, entre otras.
Para calificar para Medicare tenemos que cumplir ciertos requisitos:
Al cumplir 65 años, si es ciudadano estadounidense o con residencia permanente, por lo menos por 5 años consecu tivos y ha tenido una vida laboral pagando los impuestos (taxes) de medicare y acumulando los puntos reglamentar ios (40 puntos mínimos).
Si tiene alguna discapacidad aprobada, 24 meses después de la aprobación podrá tener la cobertura de Medicare, si cumple con los requisitos establecidos. En algunas otras circunstancias especiales podríamos accesar más rápido a la cobertura de Medicare si la persona padece de fallo renal y esclerosis múltiple.
Nos ofrece el 80% de cobertura en el hospital mientras esta mos internados. El beneficiario de Medicare es responsable del 20% y deducibles. El deducible de la parte A para 2023 es de 1,600.00 dólares, válidos para un periodo de 60 días. Después de 60 días estando internado el cliente pagará un co-pago por día. Algunos servicios en la estadía del hos pital tendrán un co-pago específico dependiendo de cuánto tiempo estemos en el hospital. Medicare parte A también paga por servicios en el Hospicio o en un Centro de Reha bilitación.
Si usted o su esposo(a) han pagado los impuestos (taxes) de Medicare en su vida laboral, por lo general no tendrán que pagar una prima de la parte A. Si no cumple estos requisitos tendrá la opción de pagar una prima mensual. Si cumple con los requisitos establecidos para calificar para la parte A, (al menos 40 créditos) su inscripción será au tomática al cumplir 65 años.
Medicare Parte B: Medicare parte B le ofrece el 80% de cobertura para las vis itas a doctores primarios y especialistas, así como también servicios de entrada y salida el mismo día en el hospital (servicios ambulatorios). Los beneficiarios de la parte B serán responsables de pagar el 20% de algunos de los servi cios recibidos y el deducible de la parte B una vez por año. Para 2023 el deducible de la parte B se espera que sea de 226.00 dólares.
La parte B tiene una prima o pago que será deducida de su cheque del seguro social. Actualmente la prima de la parte B es de 170.10 por mes para 2022 y se espera un 3% menos para 2023. La prima de la Parte B bajará a 164.90 a partir de enero 1º de 2023. Algunas personas califican para que el Estado pague parte o toda la prima de la parte B, dependiendo de sus ingresos y otros re cursos. Hay otras personas que tendrán que pagar una prima más alta por la Parte B, si sus ingresos sobrepas an los límites establecidos por el Seguro Social. Para 2023 el límite de ingresos para pagar la prima más baja es 97,000.00 dólares anuales para una persona soltera y 194,000.00 para una pareja. Si sus ingresos sobrepasan estos montos, la prima de la parte B será ajustada dependiendo de su ingreso.
Hay personas que pueden retrasar el comienzo de la parte B, sin ser multados, si aún están trabajando y su empleador ofrece una cobertura médica que no requiere la parte B, siempre que esta cobertura sea tan buena como la cobertu ra de Medicare. Si las personas no se registran en la parte B cuando primero califican y no tienen esta excepción de estar cubiertos por el empleador, pagarán una penalidad del 10% de incremento en la prima mensual, por cada 12 meses de retraso en la registración.
Note que Medicare parte A y B no ofrecen cobertura de medicamentos en las farmacias. Para este fin, las personas deben adquirir un Plan de Recetas, o Medicare parte D, o adquirir las recetas a través de un plan de Medicare Advan tage o Medicare parte C.
También es importante notar que Medicare no cubre el 100% de los servicios ofrecidos en el Hospital y en los doc tores, por eso es importante conocer los planes disponibles para complementar las coberturas de Medicare
Cubrirá los medicamentos recetados por el doctor, en las farmacias. Hay múltiples planes de recetas; cada uno cuen ta con un formulario o lista de medicamentos cubiertos por ese plan. Cada medicamento es a su vez clasificado en dif erentes categorías, dependiendo si es genérico o nombre de marca original. Consecuentemente, cada medicamento podrá pagar un co-pago o porcentaje, dependiendo de su categoría. Los planes de recetas tendrán una prima o pago mensual y usualmente un deducible al inicio del año. Para 2023 el deducible standard del plan D es de 505.00 dólares.
Antes de enrolarse en un plan de recetas es importante re visar todos los aspectos importantes para usted, como pri ma mensual, deducible anual, co-pagos de medicamentos genéricos y de marca original y verificar si sus medicamen tos están en el formulario del plan en cuestión.

Los planes de Medicare Advantage son ofrecidos por com pañías de seguros privadas que tienen contrato con Medi care para ofrecer planes. Por ley los planes de Medicare Advantage tienen que ofrecer todos los servicios ofrecidos
por Medicare y ofrecen algunos servicios adicionales que no son ofrecidos por Medicare. También el Medicare Ad vantage combina los servicios de Medicare Parte A, (Hos pital) Medicare Parte B (Doctores) y en muchos casos Medicare Parte D y algunos beneficios adicionales. Ejem plo de esos servicios son: Beneficios Dentales, transporte para citas médicas, productos de ventas sin recetas (OTC), los planes de recetas o Medicare parte D, Membresía de gimnasios, entre otros. Cada plan de Medicare Advantage tiene su network o lista de doctores y normas que el ben eficiario debe seguir.

Medicare complementario o Medigap plans. Los planes de Medicare Complementario cubrirán todo o parte del 20% y deducibles no cubiertos por Medicare, dependiendo del plan escogido. En esta situación, Medi care será seguro primario y Medicare complementario será secundario. Cuando escogemos este tipo de plan se ten drá que escoger un plan de recetas o Medicare parte D, de forma separada. Además, cualquier beneficio adicional como dental y visión, tendrá que ser añadido como plan adicional y pagará una prima adicional mensual.
Mercado de Seguros ACA (Obama Care)
Si tiene menos de 65 años y aun no califica para Medicare, podría aplicar en el Mercado de Seguros, u Obama Care para familias e individuos. Este Periodo Abierto estará también disponible desde noviembre 1º y hasta enero 15 del 2023. Texas es uno de los estados con mayor número de personas no aseguradas. Muchas familias e individuos que podrían calificar para planes de excelentes coberturas y precios, pudieran estar perdiendo la oportunidad de dis frutar esta protección por no aplicar a tiempo. Asegúrese de revisar su plan de salud para 2023.
Sea que decida escoger un Plan D, Supplement o Medicare Advantage, aquí en Jimco Insurance Services le podemos ayudar a encontrar el plan que mejor se ajuste a sus necesi dades. Representamos a la mayoría de las compañías pre sentes en nuestra área. Llámenos hoy y Regístrese para una de nuestras presentaciones de planes para 2023 o haga una cita personal al 956-467-6994 o al 956-631-2202.
Nosotros no representamos todos los planes presentes en su área. Cualquier información proporcionada estará lim itada a los planes que representamos en su área. Por favor contacte a Medicare.gov or 1-800- Medicare para obtener todas sus opciones.
Al llamar a estos números su información será proporcio nada a un agente de seguros con licencia.


NotiPress.- Investigadores de la Universidad de Melbourne revelaron que el trabajo no remunerado está relacionado con una peor salud mental en las mujeres, pero los efectos son menos evidentes para los hombres. De acuerdo con 11 de los 14 estudios revisados, las mujeres presentaron un aumento de síntomas depresivos o angustia laboral con el aumento de las demandas laborales no remuneradas.
México cuenta con 69 mil 128 mujeres que realizan un trabajo no remunerado, según datos del Instituto Nacional de Estadística y Geografía (INEGI). Asimismo, el INEGI de stacó que 32.5 por ciento de los mexicanos se han sentido deprimidos alguna vez en su vida.

La investigación, publicada en The Lancet Public Health, reunió y evaluó evidencia que examina la asociación de género entre el trabajo no remunerado y la salud mental.

En ese sentido, se revisaron 14 estudios, dando un total de más de 66 mil 800 trabajadores a nivel mundial.
Cinco estudios analizaban el trabajo no remunerado, tales como en algunos casos del cuidado, servicios de salud y educación. Por su parte, nueve examinaron el tiempo de trabajo doméstico y, entre esos, cuatro analizaron el cuida do de los niños.

Entre los resultados de los investigadores, se encuentra la penalización económica experimentada por las mujeres al asumir casi toda la carga laboral. El asumir gran parte de
dicha carga, lleva consigo un costo para la salud mental. Por una parte, en 11 de los 14 estudios examinados, las mujeres afirmaron tener alguna repercusión en su salud mental. Sin embargo, los hombres sólo informaron asocia ciones negativas en tres de los 12 estudios.
Jen Erving, líder de la investigación comentó que la doble carga de trabajo pagado y no pagado expone a las mu jeres a un riesgo mayor de sobrecarga, pobreza de tiem po y peor salud mental. Según lo explicado, las mujeres intercambian horas de trabajo remunerado para cumplir sus responsabilidades laborales no pagadas de forma de sproporcional.
En ese sentido, el estudio busca destacar la necesidad de una mayor atención y una acción significativa para estim ular una mayor equidad en la división de trabajo no re munerado. Erving aseguró que si los hombres asumen su parte equitativa hay una mayor potencialidad de mejorar la salud mental de las mujeres.
Adicionalmente, los investigadores dicen que es necesa rio hacer cambios urgentes sustantivos en determinadas políticas. Entre las políticas que deben de cambiar están el cuidado universal de los niños y la normalización de arreglos laborales flexibles para hombres.
Sin embargo, concluyeron que la revisión necesita más investigaciones en diferentes longitudes de alta calidad.
Además, se debe de comprender mejor los matices dentro de las diferentes áreas del trabajo no remunerado, así como la necesidad de un enfoque coherente sobre cómo se define y mide el trabajo no pagado.

El trabajo no remunerado puede ser un factor para el deterioro de la salud mental en mujeres, revela nueva investigación de la Universidad de Melbourne.

 Por el Dr. Luis Montel
Por el Dr. Luis Montel
Las emociones y el cuerpo están más vin culados de lo que creemos. Cada emoción genera una onda expansiva de destruc ción, degeneración y depresión, si se trata de una emoción negativa. Y si es positiva, generará reconstrucción, regeneración y bienestar.
Entonces, hay que cuidar las emociones, ya que son las mensajeras enviadas a cada célula para comunicar si debe seguir mul tiplicándose y preparándose, o justo lo contrario. Por tanto, debemos vigilar los mensajes que enviamos al cuerpo. La felicidad es la emoción de no necesitar nada, disfrutar el presente con lo que ten emos, valorar estar vivos y respirar. Todo lo otro que nos cuenten es aprendido so cialmente, para nunca estar contentos, ya que siempre faltará algo. Y eso nos hará infelices y generará emociones negativas.
Hay que recordar que las emociones se generan por dos únicas vías: los hechos y las palabras. Los hechos son las cosas que nos pasan, y las palabras, la forma en que nos los contamos.
Las emociones positivas generan: mejor trabajo del sistema inmunológico, menor gasto de energía por el cerebro, menos producción de toxinas, regulación de los biorritmos biológicos y el ritmo circadia no, mejor etapa de sueño profundo, mejo ra los síntomas de enfermedades degener ativas, nos hacen sentir menos dolor y se
repara mejor el ADN. También, nos salen menos arrugas, aumentamos mejor la masa muscular, quemamos mejor la grasa y el funcionamiento de la insulina es mucho mejor.
Claves para ser felices:
-No perder la ilusión nunca
-No alejarse de los amigos de toda la vida
-No priorizar el trabajo antes que la familia, el amor y la salud
-No llegar a la fatiga mental o física
-Eliminar o minimizar las situaciones estresantes
-Escoger bien a la pareja. No sólo por el aspecto físico, sino por el in tercambio emocional

Casi el 50% de las epidemias en Estados Unidos entre 1973 y 1987 fueron ocasionadas por productos de origen ani mal
NotiPress.- La Administración de Alimentos y Medicamentos de Estados Unidos (FDA, por sus siglas en inglés), señaló que una de cada 6 personas sufre de enfermedades transmitidas por los alimentos (ETA) al año. Anualmente, ese tipo de enfermedades
Enfermedades transmitidas por los alimentos son padecidas por 1 de cada 6 personas en Estados Unidos; productos de origen animal, principales causantes.
provocan 128 mil hospitalizaciones y tres mil muertes.
De acuerdo con la Organización Panamer icana de la Salud (OPS), los productos de origen animal fueron los causantes en el 48 por ciento de las epidemias ocurridas por alimentos entre 1973 y 1987 en Esta dos Unidos. Es decir, la carne bovina, carne porcina, huevos, carne de aves, crustáceos, pescados, moluscos, o productos lácteos causan primordialmente las ETA. Una ETA ocurre cuando las toxinas de un patógeno están presentes en un alimento. Sin embargo, la presencia del patógeno no significa que la enfermedad ocurrirá, pues deberá de estar presente en una cantidad suficiente para causar una infección o tener las características para desarrollar el agen te.
Consumir bacterias peligrosas contenidas en alimentos pueden provocar enferme dades uno a tres días después de consumir un producto contaminado. No obstante, la FDA indica que la enfermedad puede ocur rir 20 minutos o hasta 6 meses después de consumir alimentos infectados.
-Luchar cada día, pero ser feliz con lo que se tiene
-No dejar de superarte y actualizarte para siempre estar activo
-Hacer un balance sobre si lo que hacemos nos gusta en verdad
-Complacerte a ti mismo. No esperes a que nadie te premie
-Si te han pasado cosas malas, como divorcio o fallecimiento de famil iares, recordar lo bueno que obtu viste y lo que te enseñaron
-No confiar en las redes sociales, ya que están llenas de infelices que simulan no serlo.
-Busca una afición. Nunca es tarde para aprender o desarrollarla
-Haz el ejercicio de reír para activar los receptores cutáneos y enviar el estímulo al cerebro
Hay que ser egoísta con nuestra felicidad y no dejar que nadie nos la corte o robe. Así viviremos mejor, más sanos e ilusionados.
www.DrLuisMontel.com
Si bien, muchas de las personas se recu peran en un período corto, algunos pueden desarrollar problemas de salud crónicos o incluso mortales. La FDA destacó que las mujeres embarazadas, niños, adultos de la tercera edad y personas con sistemas in munes debilitados tienen un mayor riesgo.
Por ello, la organización estadounidense recomienda seguir cuatro pasos: limpiar, separar, cocinar y enfriar. Es necesario la varse las manos y las superficies con fre cuencia, asimismo, las frutas y verduras deben de ser enjuagadas.
También es importante separar la carne cru da de otros alimentos; para esto se deberán de poner en bolsas y utilizar tablas para picar diferentes. Los productos deben de ser cocinados a las temperaturas correctas, lo cual se logrará por medio de un termómet ro o hirviendo el alimento. Finalmente, se deben refrigerar los alimentos inmediata mente después de usarse.
Los síntomas de las ETA pueden incluir:
Dolor abdominal
Fiebre

Barcelona (España), (EFE).- Una investi gación internacional ha descubierto cómo se comunica con las células humanas el coronavirus SARS-CoV-2 y ha encontra do más de 200 interacciones de proteína a proteína entre el virus y las células que toca.
El estudio, que publica la revista “Nature Biotechnology” y en la que ha participa do el Instituto de Investigación Biomédica (IRB) de Barcelona, se planteó responder a estas tres preguntas: ¿Cuáles son exacta mente las interacciones moleculares entre el virus causante de Covid-19 y su huésped humano? ¿Cómo pueden nuestras difer encias genéticas causar diferentes cursos de la enfermedad? ¿Y cómo difieren las variantes del virus, aún emergentes, en sus interacciones con el huésped?
La investigación la ha llevado a cabo un consorcio internacional, dirigido por Pascal Falter-Braun, director del Insti tuto Helmholtz de Biología de Redes de Múnich (Alemania), e incluyó equipos de Canadá, Estados Unidos, Francia, España y Bélgica.
Científicos del laboratorio de Bioin formática Estructural y Biología de Redes del IRB de Barcelona, dirigido por Patrick Aloy, han contribuido analizando la red de interacciones entre el virus y las células humanas.
Ente otras cosas, los científicos han des cubierto que muchas proteínas virales muestran una preferencia de unión a do minios estructurales específicos presentes en varias proteínas humanas.
“Comprender mejor las interacciones del virus con nuestras células es clave para evitar esas interacciones y, así, la infec ción. De hecho, el consorcio ya ha proba do con éxito algunos compuestos con este fin. Estudios posteriores evaluarán cómo la variabilidad genética de los huéspedes humanos afecta a estas interacciones”, avanzó Aloy.
A diferencia de los anteriores estudios so bre asociaciones proteínicas, ahora han podido identificar con precisión los con

tactos proteínicos directos entre el virus y el huésped.
Al examinar de cerca este conjunto de interacciones proteicas directas (o “con tactoma”), el equipo encontró cadenas de conexiones entre las proteínas víricas y los genes humanos relevantes para la infec ción.
Por ejemplo, pudieron rastrear conexiones entre ciertas proteínas del SARS-CoV-2 y proteínas humanas codificadas por los genes que se han relacionado con una may or probabilidad de Covid-19 grave en otros estudios.
También encontraron conexiones entre las proteínas virales y los genes implicados, por ejemplo, en trastornos metabólicos como la obesidad y la diabetes.

Ya se sabía que las diferencias genéticas en los humanos desempeñan un papel im portante en el curso y la gravedad de una infección por Covid-19, pero ahora, gracias a identificar los puntos de contacto molec ulares, es posible examinar los mecanismos subyacentes, según los investigadores.
Entre los primeros datos se encuentra la demostración de que importantes vías de señalización inflamatoria son activadas directamente por el virus, unos contactos que podrían explicar la exagerada reacción inflamatoria que desempeña un papel im portante en los casos graves de Covid-19.
También han visto que los contactos proteí na-proteína no sólo apuntan a impactos en la función de las células humanas y el
sistema inmunitario humano, sino también en la función del SARS-CoV-2, incluida la velocidad de replicación del virus.
Tras ver la influencia mutua de las conex iones proteína-proteína, los investigadores ha elaborado un mapa sistemático de con tactos que apunta a muchas posibles dianas farmacológicas.
Los científicos han podido confirmar, por ejemplo, que la proteína humana USP25 es reclutada para ayudar a ciertos procesos virales y que su inhibición reduce significa tivamente la multiplicación del virus.
Han usado la tecnología más avanzada para trazar el mapa de contactos que, según explican, fue como resolver un enorme rompecabezas.
Los investigadores examinaron y visualiza ron sistemáticamente las interacciones de unas 30 proteínas víricas, cada una de ellas con unas 17.500 proteínas humanas inter rogando a 450.000 pares de proteínas, una tarea ingente que sólo pudieron llevar a cabo con la ayuda de la robótica, el análisis computacional y métodos de biología mo lecular y de inteligencia artificial.
Creen que el mapa del contactoma ser virá de plataforma para que la comunidad científica estudie con más detalle las inter acciones individuales y comprenda su im pacto en los mecanismos moleculares y la progresión clínica, y así descubra puntos de partida para nuevas estrategias terapéuti cas.
Unete a nuestra misión de brindar felicidad, alivio y esperanza a todos nuestros hogares.
Usted podría ser elegible para obtener hasta $500 en bono de inicio.Fotografía de archivo de personal técnico de laboratorio preparando unas muestras para analizar. EFE/Javier Cebollada.
NotiPress.- Según un estudio elaborado por científicos de la Universidad de California, Berkeley, la falta de sueño puede perjudi car la conciencia social básica, teniendo actitudes antisociales o de egoísmo. Dicho factor no sólo daña el bienestar mental y físico de un individuo, sino también com promete los lazos entre personas e incluso el sentimiento altruista de toda una nación. De esta forma, los científicos demostraron que tras el comienzo del horario de verano, y perder una hora del día, el 10 por ciento de las personas comienza a tener dichas al teraciones. Mientras, las personas que res iden en estados donde no se cambian los relojes, o cuando los estados regresan a la hora estándar en el otoño, no presentaban actitudes antisociales o de egoísmo por la falta de sueño.
El estudio fue dirigido por el científico in vestigador de UC Berkeley Eti Ben Simon y Matthew Walker, profesor de psicología de UC Berkeley. “Este nuevo trabajo dem uestra que la falta de sueño no sólo daña la salud de un individuo, sino que degrada las interacciones sociales entre individuos y, además, degrada el tejido mismo de la so ciedad humana. La forma en que operamos como una especie social, y somos una espe cie social, parece depender profundamente de cuánto dormimos”, señaló Walker.
“Estamos empezando a ver más estudios, incluido éste, donde los efectos de la pérdi
da de sueño no sólo se detienen en el indi viduo, sino que se propagan a quienes nos rodean. [...] Si no duerme lo suficiente, no sólo perjudica su propio bienestar, sino tam bién el bienestar de todo su círculo social, incluidos los extraños”, esbozó Ben Simon. Frente a tal situación, el estudio se realizó mediante tres evaluaciones separadas en donde se analizó el impacto de la falta de sueño en la disposición de las personas a
ayudar a los demás. Así pues, el primer estu dio fue elaborado con la participación de 24 voluntarios sanos en una resonancia mag nética funcional. En la cual, escanearon sus cerebros después de ocho horas de sueño y después de una noche sin dormir. Tras ello, descubrieron que las áreas del cerebro que se activan cuando las personas sienten em patía por los demás, estaban menos activas después de una noche de insomnio.
Asimismo, en la segunda evaluación rastre aron a más de 100 personas en línea duran te tres o cuatro noches. Así pues, durante este tiempo midieron la calidad de su sueño y luego evaluaron su deseo de ayudar a los demás. “Aquí encontramos que una dis minución en la calidad del sueño de una persona de una noche a la siguiente predijo una disminución significativa en el deseo de ayudar a otras personas de un día posterior al siguiente”, aseguró Ben Simon. Agregó, “aquellos que durmieron mal la noche anterior fueron los que informaron estar menos dispuestos y ansiosos por ayudar a los demás al día siguiente”.
Finalmente, la tercera parte del estudio in volucró la extracción de una base de datos de 3 millones de donaciones caritativas en Estados Unidos entre 2001 y 2016. Sin em bargo, por el cambio del horario de verano y la pérdida de una hora de se encontró una disminución del 10% en las donaciones. “Cuando las personas pierden una hora de sueño, hay un claro impacto en nuestra bondad humana innata y nuestra moti vación para ayudar a otras personas que lo necesitan”, opinó Walker.
Ante tal escenario, los científicos Walker y Ben Simon mostraron que la falta de sueño obligaba a las personas a retraerse social mente y aislarse más socialmente. La falta de sueño puede generar actitudes antisocia les o de egoísmo y se pueden contagiar tal y como una gripe. “Es hora de que como so ciedad abandonemos la idea de que dormir es innecesario o un desperdicio y, sin sen tirnos avergonzados, comencemos a dormir lo que necesitamos”. “Es la mejor forma de bondad que podemos ofrecernos a nosotros mismos, así como a las personas que nos rodean”, concluyó el científico Ben Simon.
extiende de octubre a mayo. La Academia Americana de Pediatría recomienda que todos los niños de seis meses —o más— se vacunen contra la influenza este otoño, ya que las vacunas siguen siendo la mejor manera de prevenir en fermedades graves y de mantener a los niños en las aulas.
Todos los niños de seis meses a ocho años que reciben la vacuna contra la influenza por primera vez, que recibieron sólo una dosis antes del 1 de julio de 2022 o cuyo estado de vacunación se desconoce, deben recibir dos dosis con al menos cuatro semanas de diferencia. Todos los demás niños deben recibir una dosis esta temporada.
Se necesitan aproximadamente dos semanas después de la inyección para desarrollar inmunidad. Los niños que son elegibles para la vacuna contra la influenza y el Covid-19, pueden recibirlas al mismo tiempo.
Las mujeres embarazadas pueden recibir la vacuna contra la gripe en cualquier momento para protegerse a sí mismas y a sus bebés. La vacunación contra la influenza durante la lactancia materna es segura para ambos.

¿Qué vacunas contra la influenza están dis ponibles?

Hay dos tipos. La primera es la que muchas personas lla man la “vacuna contra la gripe”. La segunda viene en forma de aerosol nasal. Se debe administrar cualquier vacuna au torizada disponible este año, y apropiada para la edad de un niño. No hay preferencia.
¿Pueden los niños recibir una vacuna contra la influenza y otras vacunas al mismo tiempo?
Sí.
¿Qué pasa con las alergias a las vacunas contra la gripe?
Un niño que tuvo una reacción alérgica después de una va cuna contra la gripe en el pasado, debe ser visto por un alergólogo. Este puede ayudar a los padres a decidir si su hijo debe recibir su vacuna anual. Un niño con anteced entes conocidos de alergia al huevo, puede recibir la vacu na contra la gripe.
* Robert Uriel ejerce la pediatría desde hace 36 años. https://southfloridapeds.com/
No sólo daña la salud de un individuo, la falta de sueño puede degradar las interac ciones sociales entre individ uos tras actitudes antisociales o de egoísmo.
Ciudad de México, (EFE).- El embajador de Estados Uni dos en México, Ken Salazar, aseguró que se mantienen las consultas energéticas con México en el marco del Trata do comercial México, Estados Unidos y Canadá (T-MEC), después de que el presidente mexicano, Andrés Manuel López Obrador, anunciara la pasada semana que Washing ton había desistido.
"El proceso sigue, eso no ha cambiado. Es consulta. El T-MEC es un marco legal entre los tres países, y se tiene que dar seguimiento", afirmó Salazar en conferencia de prensa desde la embajada estadounidense en la capital mexicana. El diplomático se refería a la solicitud de consultas realiza da por la Oficina del Representante de Comercio Exterior de EE.UU. en julio, bajo el argumento de que las regula ciones mexicanas en el sector energético discriminaban a las empresas privadas y violaban el pacto comercial.
Sus palabras contrastan con las del presidente López Obra dor, quien afirmó el viernes pasado que EE.UU. "ha decido no dar el paso hacia un panel de mediación" en torno a las controversias sobre energía.
Por otro lado, Salazar descartó que la reciente renuncia de Tatiana Clouthier, como secretaria de Economía, modifique
las conversaciones comerciales entre ambos países.
"Trabajamos muy bien, nosotros con ella (Clouthier) y son decisiones del Gobierno de México y seguiremos trabajando con el Gobierno del presidente Andrés Manuel López Ob rador y su gabinete, con el acuerdo más fundamental, que es el reconocimiento de que México, EE.UU. y Canadá son la fuerza (económica) más poderosa del mundo", afirmó.
Asimismo, Salazar insistió en que EE.UU. y México siguen colaborando "estrechamente" para quebrar las cadenas de bandas de criminales trasnacionales que trafican con mi grantes desde Suramérica y Centroamérica hacia la Unión Americana.
Precisamente, el T-MEC y la migración serán dos de los ejes de la próxima cumbre trilateral que acogerá México el próximo mes y a la que asistirán el presidente de Estados Unidos, Joe Biden, y el primer ministro canadiense, Justin Trudeau.
El embajador de Estados Unidos en México, Ken Salazar, habla durante una rueda de prensa en Ciudad de México (México). EFE/Mario Guzmán

En el marco del 65 aniversario de su fun dación, la Facultad de Medicina Veterinar ia y Zootecnia (FMVZ) de la Universidad Autónoma de Tamaulipas (UAT) puso en marcha el Tercer Congreso Internacional, cuyo evento lleva el nombre de la Dra. Ga briela Sarahí Luna Castro, en un homenaje póstumo a la catedrática e investigadora de esta casa de estudios. Al evento inaugural acudió, en represent ación del rector de la UAT, C. P. Guillermo Mendoza Cavazos, la Dra. Mariana Zerón Félix, secretaria de Investigación y Posgra do; asimismo, estuvieron presentes, el MVZ Dámaso Anaya Alvarado, secretario estatal
de Desarrollo Rural, en representación del gobernador de Tamaulipas, Dr. Américo Vil larreal Anaya; y el Dr. Flaviano Benavides González, director de la FMVZ. De igual forma acompañaron el evento, el Ing. Homero García de la Llata, presiden te de la Confederación Nacional de Orga nizaciones Ganaderas; la Dra. María de la Luz Vázquez Sauceda, jefa de la División de Estudios de Posgrado de la facultad; y el mayor médico cirujano Julio César Teco Pérez, comandante de la 48 zona militar, entre otras autoridades.
Fermín y Benjamín aprendieron los secre tos de los teclados en el seminario menor de Durango. Pero lo suyo no era el claustro monacal

Fermín y Benjamín Ramírez, fueron inter nados en el seminario menor de Durango. Los domingos, después de misa, podían convivir con su familia y regresar para la liturgia del rosario. En mayo, las niñas of recían flores a la virgen y en junio el turno era de los niños. Su madre falleció siendo menores, y en el funeral los coros del semi nario acompañaron a la señora con sus an gelicales salmos en el Panteón de Oriente. Los hermanos aprendieron los secretos de los teclados. Además, Benjamín tiene una voz de barítono que lo colocaba al frente de los coros. No pocas de las señoronas de la catedral contrataban a los hermanos para armonizar sus fiestas, serenatas o respon sos.
El padre rector envió a Fermín al Seminario
Conciliar de México y de allí a la Ciudad Eterna a conocer los secretos del Vaticano y cantar en una misa solemne el Ave María y alguna tonadilla a la Morena del Tepeyac. Pero lo suyo no era el claustro monacal. Se las ingenian cuando un paisano los lleva a California a cantar en una boda. Se quedan allá y a luego, se van a Las Vegas, donde se relacionan con otros paisanos, incluso incursionan en la Catedral del Ángel de la Guarda, aderezados por el órgano monu mental de la sede católica de Nevada. Hace unos años, se celebró el 450 aniver sario de la fundación de Durango. Con la fama que tiene Fermín de buen intérprete, fue invitado y ganó el concurso con un himno alusivo.
Los hermanos van por el mundo inter pretando lo mejor de la música sacra y de la mexicana. Lo suyo es la armonía, que aprendieron en el claustro en los años de adolescentes. Sus vocaciones pensaron, se realizarían en el púlpito, pero la vida los reubicó como artífices e intérpretes de la música que gusta a las mayorías, en inglés o español.
Fermín sigue en la música y Benjamín está ahora dedicado a bienes raíces, pero am bos siguen vinculados a su familia en el estado de Durango.
 Por Enrique KoganSyndicate Auto News Wire
Por Enrique KoganSyndicate Auto News Wire
Volkswagen Commercial Vehicles ya ha comenzado las ventas en Europa y los prim eros vehículos se entregarán a sus propi etarios este otoño. Hay dos versiones: El ID. Buzz MPV y la furgoneta ID Buzz Cargo, siendo un vehículo de vanguardia para fa milias, personas activas y empresas.
El estilo es claro: icónico, potente y amable. Los voladizos estrechos de la carrocería aerodinámica (cd 0,29) se corresponden visualmente con las ágiles características de conducción.
El motor eléctrico de 150 kW (201 caballos de fuerza) hace que su par máximo de 310 Nm (229 lb-ft) esté disponible de inmedi ato.
Gracias a la transmisión de las ruedas tras eras (como en el T1 Bus original), la direc ción también está libre de cualquier influ encia del sistema de transmisión. La batería de 77 kWh (neto) está integrada en lo pro fundo del piso del vehículo para ayudar a bajar el centro de gravedad y reduce el bal anceo al mínimo.
El peso se distribuye centralmente dentro del vehículo, lo que garantiza un manejo neutral. Todo esto, además de un círculo de giro cerrado de solo 11,1 metros (36,4 pies), lo convierte en el ID. Buzz es el ve hículo ideal también para conducir en la ciudad.
En el ciclo combinado WLTP, la autonomía del ID. Buzz es de hasta 263 millas; El ID. Buzz Cargo sube hasta 264 millas La batería se puede cargar en casa, en el trabajo o en puntos públicos de carga de CA con un cargador de a bordo de 11 kW. En las estaciones de carga rápida de DC, ID. Buzz puede generar hasta 170 kW, lo que permite una carga del 5 al 80 por ciento en solo 30 minutos. Los vehículos también pueden car garse a través de ‘Plug & Charge’; que per mite la activación y facturación automática. Están disponibles nuevos sistemas de asis tencia al conductor, como Travel Assist con utilización de datos de enjambre y cam bio de carril asistido. Park Assist Plus con función de memoria para maniobras au tomáticas en el garaje de casa, una cochera o un espacio en el estacionamiento de la empresa también es nuevo. En Europa, muchos sistemas de asistencia al conductor se incluyen de serie, como Car2X (advierte de peligros en las inmed iaciones) y Front Assist con seguimiento de
peatones y ciclistas (Frenado de emergen cia autónomo).
Los ID. Buzz salen de fábrica con el Volk swagen ID más reciente, la versión de soft ware 3.2 que se puede actualizar simple mente por aire.
Conceptualmente el ID. Buzz añade otro elemento al motor eléctrico
Carsten Intra, CEO de la Junta Directiva de la marca Volkswagen Commercial Vehi cles, dice: “Ningún otro fabricante de ve hículos tiene un dúo monovolumen y fur goneta totalmente eléctrico comparable en su cartera. La tecnología de vanguardia y el concepto de diseño del ID.Buzz y el
ID.Buzz Cargo son únicos a nivel mundial”. “El ID. Buzz atrae a todo tipo de clientes diferentes: familias, personas que necesitan mucho espacio para su pasatiempo, además de dueños de negocios y oficios manuales”, dice Thomas Schäfer, miembro de la junta directiva de Volkswagen AG y director del grupo de marcas de alto volumen. “Las per sonas que optan por el ID.. Es probable que el ID.Buzz provenga tanto de un SUV o del mundo de las camionetas como de los fanáticos de los autobuses que quieren volverse eléctricos. Por lo tanto, este modelo tiene una importancia excep cional para Volkswagen y Volkswagen Com
A 185,5 pulgadas, los dos ID. Los modelos Buzz tienen la misma longitud. La distan cia entre ejes también es larga, con 177,7 pulgadas. Se hace un uso óptimo del espa cio entre los ejes. Dependiendo de la espe cificación, el ID. Buzz y el ID. Buzz Cargo miden entre 75,9 y 76,8 pulgadas de alto. Excluyendo los espejos retrovisores, ambos modelos tienen 78.1 pulgadas de ancho. Con 24,9 pulgadas de alto, el umbral de carga del ID. Buzz y el ID/ Buzz Cargo son agradables y bajos.
Como monovolumen, el espacioso ID. Buzz está idealmente diseñado para el tiempo libre como para el uso comercial. El con ductor y el pasajero del asiento delantero se sientan en asientos individuales equipados con apoyabrazos interiores ajustables es tándar. En la parte trasera, el banco de tres plazas está partido 40:60 y sus respaldos son abatibles.
Para crear espacio adicional para las pier nas o para el equipaje, también es posible mover las dos partes del banco del asien to 5,9 pulgadas a lo largo. Las dos puertas corredizas del MPV vienen de serie. Con cinco personas a bordo, hay 39,6 pies cúbi cos de espacio para equipaje detrás de la se gunda fila que se expande a 77,9 pies cúbi cos cuando se pliega la segunda fila.
El ID. Buzz Cargo es una de las furgonetas más modernas del mundo
Se ofrece de serie con tres asientos en la cabina: asiento del conductor más banco doble. Si lo desea, también está disponible un asiento individual para el pasajero del asiento delantero. Detrás de los asientos hay una partición fija que separa el espacio de carga.
Esta partición está disponible opcional mente con una ventana y/o una abertura a través de la cual se pueden cargar artícu los. La capacidad del espacio de carga es de 137,7 pies cúbicos y ofrece espacio para dos europalés.
El ID. Buzz Cargo está equipado con una escotilla trasera de amplia apertura y una puerta corrediza en el lado del pasajero. La furgoneta está disponible opcionalmente con una puerta corredera adicional en el lado del conductor y con puertas traseras dobles.
Los nuevos ID. Buzz y ID. Buzz Cargo se están produciendo, junto con el nuevo T7 Multivan, en la planta de Hannover en Ale mania, la sede de Volkswagen Commercial Vehicles.

México, (Notistarz).- El cantante puertor riqueño Bad Bunny se posiciona como el artista más escuchado del mundo dentro de la plataforma de Spotify, siendo México el país que abonó más del 41% de su escuchas durante septiembre pasado.
De acuerdo con cifras de Spotify que pu blica el periódico El Universal, Benito An tonio Martínez Ocasio, mejor conocido como Bad Bunny obtuvo más de 535 mil lones de reproducciones en el mes pasado, de las cuales más de 223 millones se apor taron tan sólo en México lo cual equivaldría 41.47 por ciento de su total.
“Somos el país de Bad Bunny en cuestión de consumo musical”, aseguró Pepe Campa, locutor de Reactor 105.7 FM y Xplora 106.5 FM en entrevista con el citado rotativo y dio un motivo por al cual podría deberse ese
“Lo atribuyo a su visita a México en dic iembre (en el Estadio Azteca), la gente está muy emocionada. Si lo hemos visto en el Super Bowl en el medio tiempo o haciendo películas con Brad Pitt, sería una necedad y una estupidez darle la espalda a la realidad de que es el artista del momento en nuestro país”.

A nivel global, Bad Bunny estuvo por en cima del grupo surcoreano BLACKPINK (que ocupó el segundo lugar), y que Harry Styles, tercero. Las cifras para el puertor riqueño parece que seguirán en aumento, ya que durante octubre el género más es cuchado en México fue el urbano.

“Lo urbano es una moda que está pegando como un martillo porque principalmente los jóvenes no han encontrado una mejor opción para dejar atrás el reggaetón”, con sidera Campa sobre el hecho de que los fans lo prefieran ante otros géneros.
Miami, (Notistarz). - Los cantantes Marco An tonio Solis, Sebastián Yatra, Rauw Alejandro, Chiquis y Jesse & Joy son los primeros artistas confirmados para actuar en la ceremonia del Latin Grammy, anunció la Academia Latina de las Artes y la Grabación (LARAS).
El mexicano Marco Antonio Solís, compositor, arreglista, productor músico y director artísti co ha ganado cinco Latin Grammys, y ha sido nominado a seis Grammy, además de ser la Persona del Año 2022 de LARAS, mientras que el puertorriqueño Rauw Alejandro, quien fue nominado a Mejor Nuevo Artista en 2020, tiene un total de ocho nominaciones para los premios de este año, entre ellas Grabación del Año y Canción del Año.

Por su parte el colombiano Sebastián Yatra, an teriormente nominado al Grammy y nominado nueve veces al Latin Grammy, esta vez compiteen las categorías: Álbum del Año y Canción del Año.
Los hermanos mexicanos de Jesse & Joy, ga nadores del Grammy y de seis Latin Grammys,están nominados a Mejor Álbum Vocal Pop; y Chiquis, hija de la fenecida cantante Jenni Ri vera., ganadora del Latin Grammy está nominada a Mejor Álbum de Música Ranchera/ Mariachi.
La edición número 23 del Latin Grammy se llevará a cabo el jueves 17 de noviembre de 2022 en el Michelob Ultra Arena de Las Vegas, Nevada, Estados Unidos.
La Premiere donde se anuncian los ganadores de la mayoría de las categorías, será antes de la transmisión por la cadena latina de Univisión.
Fotos Marco Antonio Solis /TwitterPor eso Jambalaya News Louisiana, con el apoyo de Google, creó un servicio de mensajes de texto que envía alertas de noticias de última hora en español, y permite que los usuarios respondan en tiempo real.




Es apenas una de las maneras en las que colaboramos con las publicaciones locales de todo el país, para construir un futuro más robusto en la industria noticiosa.
Conoce más sobre cómo Google apoya las noticias locales en g.co/noticiaslocales
Cuando azotó el huracán Ida, las noticias cruciales no llegaron a algunos sectores de la comunidad latina de New Orleans